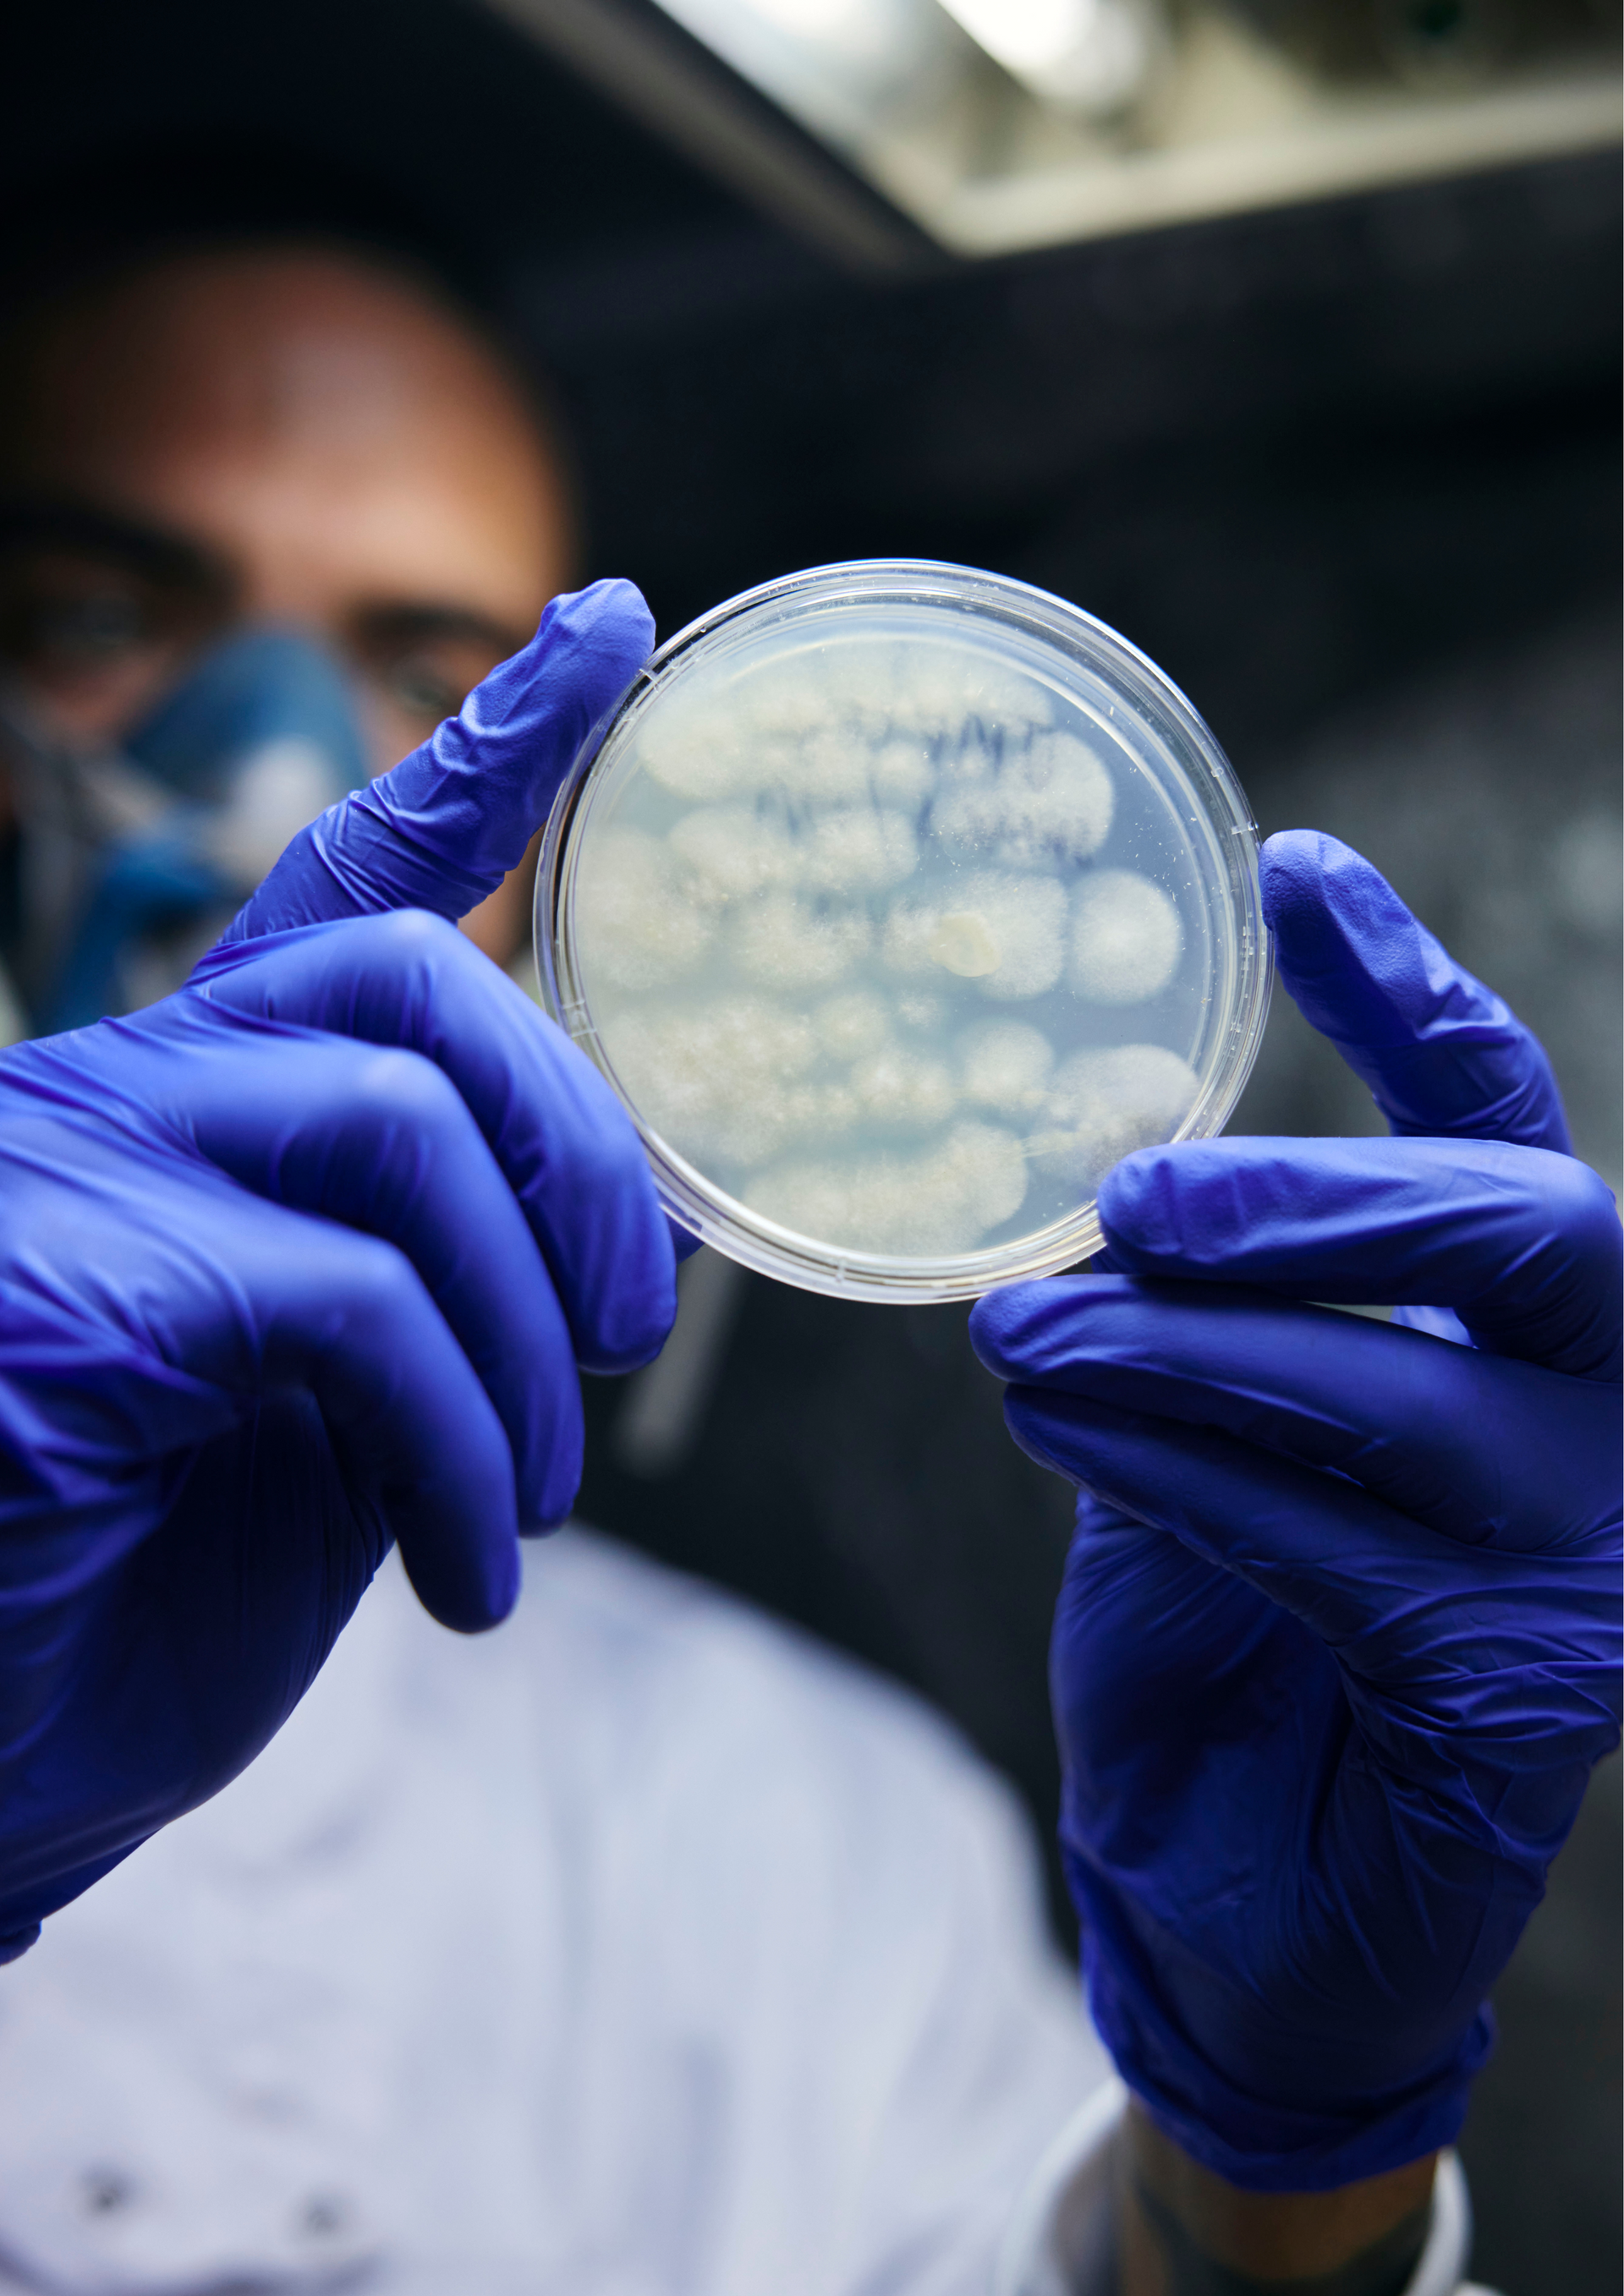

we are more than just our tinctures
As the world changes, and we are rapidly having to alter the way we navigate our existence, we believe we can learn much from the fungi world. Staying connected, listening to the earth, learning to recycle, being energy efficient, and ready to move.
Although we sell eight types of mushroom, we grow more than thirty species as well as having a genuine interest in - and hold in high regard - testing for compounds in our wild and native mushroom clones.
In our lab at the farm, we have a native library of over one hundred fungi strains, and we have grown over thirty species of mushroom. We are also commercially cultivating a number of species within the Ganoderma genus which have previously never been commercially cultivated. As well as this, we have isolated a number of monokaryots from both Hericium and Ganoderma genus and created several dozen hybrids of these. Through mass spectrometry and HPLC analysis, we are investigating - from a human health perspective - whether they exhibit higher quantities of the compounds within them.
In 2024, we officially hired our neuroscience Ph.D. student, Kaitlin Turk, to research the potential effects of our native Lion's Mane species on neurodegenerative diseases; titled ‘Neuroprotective Effects Of Edible Mushroom Extracts: A Novel Treatment For Neurodegenerative Conditions’. Under the tutelage of Dr Tim Craig, Molecular Neuroscientist and Associate Professor at UWE, our research will attempt to dissect the precise molecular mechanisms behind any therapeutic effects, including identifying the compounds in question. With the view of rolling out human clinical trials in the future, this work aims to pave the way for novel therapies for diseases that are currently incurable. Our first academic research paper looked to optimise our extraction methodology, and informed various improvements on the farm - including temperature variation, pH optimisation, and placing our ultrasonification at a different stage in the extraction process. A research paper will be published later in 2025 with these findings.
Preliminary work from the UWE lab indicates that exposure of neuronal cells to our Lion's Mane tincture enhances the process of neuronal differentiation. This is where neuronal precursor cells become mature, functional neurones - this process occurs throughout life in the human brain, but is reduced in both Alzheimer's disease and - to some extent - in normal ageing, resulting in more differentiated neuronal cells in a quicker timeframe. In addition to this, we have new data showing that Reishi extract can also enhance the growth of these neuronal cells, increase their metabolic rate and potentially protect them from damage by fatty acids. This is particularly interesting, as neuronal damage by fatty acids is one of the possible reasons for the link between Type-2 Diabetes and Alzheimer's Disease. Looking forward, Kaitlin is planning to explore how insulin sensitivity is changed by our Lions Mane tincture, as well as continuing with our differentiation assay and the ways in which our Lions Mane and Reishi tincture can influence this. She will also be proceeding with an inflammation assay which will look at neuroinflammation with human microglia, generating data by mid 2025. In addition to this, we are also pursuing several projects involving bio materials and mycoremediation; looking at potential applications for the effluent in our water systems through utilising carbon and filtration systems. This is in early stages, but we are hopefully going to close out funding for this in Q3 2025.
We have previously been conducting HPLC analysis in order to count certain compounds that are known to have benefits from a human health perspective, such as gondoic acids in Reishi. Up until recently we have been using a lab in the US, and we are now partnering with a UK lab whose primary focus will be working with us to identify and quantify these compounds in our products and in native strains. This is a long term process that is slowly but steadily developing, so stay tuned…
We have previously been conducting HPLC analysis in order to count certain compounds that are known to have benefits from a human health perspective, such as gondoic acids in Reishi. Up until recently we have been using a lab in the US, and we are now partnering with a UK lab whose primary focus will be working with us to identify and quantify these compounds in our products and in native strains. This is a long term process that is slowly but steadily developing, so stay tuned…